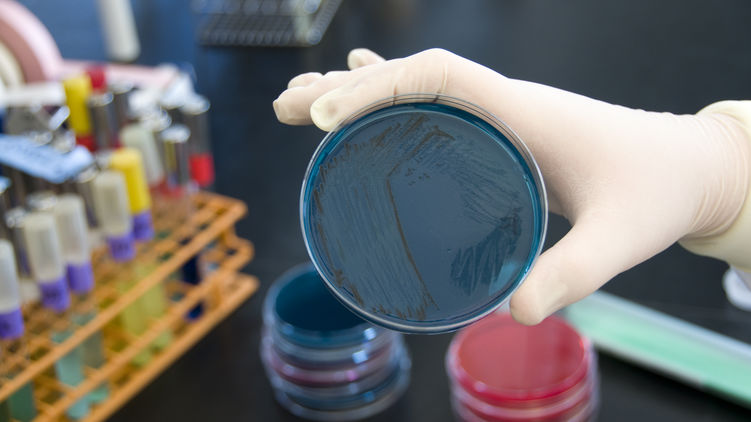

Все девять случаев подозрения на коронавирус в Украине не подтвердились
Все девять случаев подозрений на заражение коронавирусом, зафиксированных в Украине, оказались ложными, анализы проводили в вирусологической референс-лаборатории.
Об этом свидетельствует информация в Telegram-канале "Коронавирус_инфо", верифицированном Министерством здравоохранения Украины.
"В Центр общественного здоровья поступило 9 сообщений о подозрении на заболевание коронавирусом, но лабораторные исследования в вирусологической референс-лаборатории показали отрицательные результаты, ни у кого не обнаружено коронавирусной инфекции", - сказано в сообщении.
Сейчас в некоторых медицинских учреждениях Украины продолжаются учения на случай фиксации Covid-19.

Скриншот: t.me/COVID19_Ukraine
Также мы писали, что единственный подтвержденный случай коронавируса в Украине зафиксирован в Черновцах.















